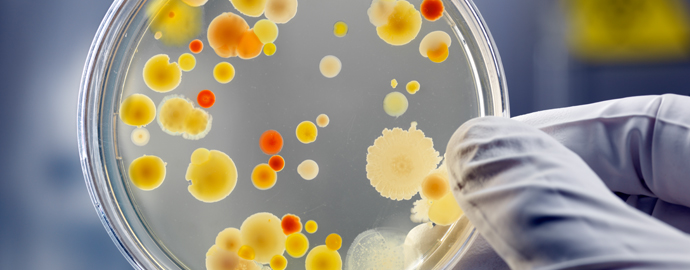
Infection and Disease

Welcome to NL Health Services’ Health Information (“Hi”) website

Here you will find information on a wide range of health and wellness topics for all ages. From family meals to family planning, from sexual health to mental health, from getting active to getting immunized – the Hi website has you covered!
We invite you to browse the categories below to find health and wellness resources for you, your family and your community.
Lorem Ipsum is simply dummy text of the printing and typesetting industry.
Research shows that programs and activities that focus on weight can cause harm. These programs and activities are based on the assumption that overweight or obese people have poor health and make unhealthy choices that need to be changed..
Events
All →
Loading events…
Virtual parenting class
Learn More